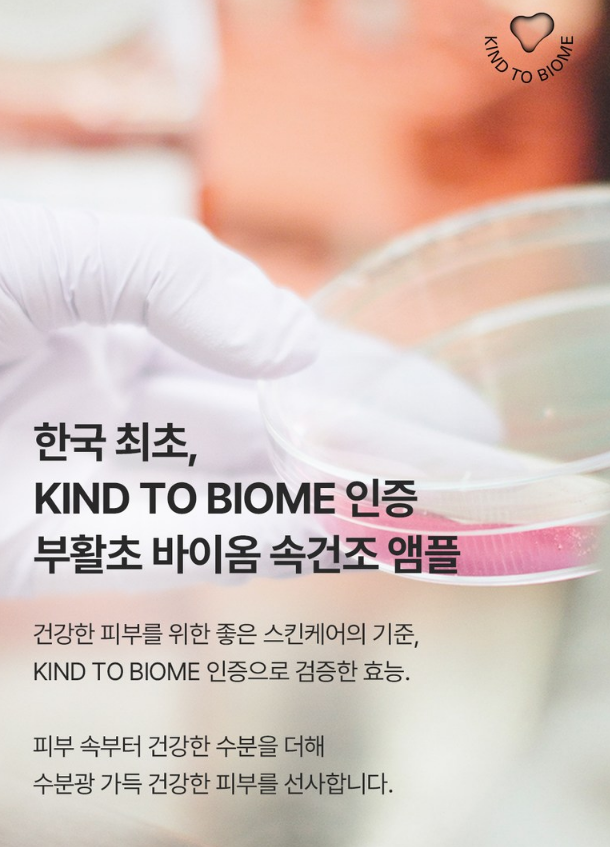

수분가득 속건조 앰플
여러분 혹시 속건조 앰플 찾고 계신가요? 시중에 판매되고 있는 앰플은 정말 셀 수도 없이 많은데요. 앰플 추천을 아무리 받아도 내 피부에 맞는 것을 찾기 어렵더라구요ㅠㅠ
특히 앰플을 처음 사용하시는 분들은 앰플 바르는 순서도 잘 모르시는 경우가 많은데요. 앰플 사용순서나 앰플 사용법 같은 것은 별로 어려움이 없어요. 그보다는 어떤 제품을 택하는지가 중요하답니다!
앰플도 종류가 참 많은데요. 수분앰플이나 탄력 앰플 추천도 많이 올라오지만, 오늘은 많은 분들의 고민인 속건조 앰플을 추천해볼까 해요! 바로 에필로우 부활초 바이옴 속건조 앰플인데요. 그럼 포스팅 시작해볼게요~
속건조 앰플 추천
에필로우 부활초 바이옴 속건조 앰플
속건조 앰플

수분 함량을 30.9% 개선하고, 피부 노화 개선 임상 완료되었으며 한국 최초 KIND TO BIOME 인증을 받은 앰플이에요.
KIND TO BIOME 인증이란?

스웨덴 스톡홀름 KIND TO BIOME 연구소에서 건강한 피부 마이크로바이옴 유지에 도움을 주는 스킨케어 제품에만 부여하는 인증이라고 해요.
건조한 피부

속까지 당기고 건조한 피부를 위해 만든 제품이에요.
부활초 69%

고농축 수분 에너지 부활초가 69% 함유되어 있어요.
이럴 때 사용해요

뭘 발라도 쉽게 건조하고 속당김이 느껴질 때, 메이크업 전 밀리지 않는 꽉 찬 수분감 케어가 필요할 때, 민감피부도 매일 사용가능한 저자극 처방이 필요할 때, 과하지 않은 유분감으로 딱 알맞게 수분광 케어를 하고 싶을 때 필요해요!
피부노화로 연결되는 속건조

물만 바른다고 촉촉해지지 않는 것처럼 피부 속까지 수분을 전달하는 힘이 더 중요해요. 피부의 수분통로 '아쿠아포린'의 기능이 약해지면 속까지 당기고 건조한 피부가 된답니다. 이 때 수분통로를 열어 원활한 수분 공급이 필요해요.
수분통로를 건강하게

부활초 속건조 앰플은 깊은 수분감으로 약해진 수분통로를 건강하게 되돌려줘요. 실제로 대한피부과학연구소에서 21명을 대상으로 피부 항노화 효능 평가를 했을 때 제품 사용 4주 후 수분 함량이 30.9%나 개선되었다는 결과가 나왔어요.
피부 노화, 흔적까지 예방

건조한 피부 속까지 건강한 수분을 더해, 깊어지는 피부 노화 흔적까지 예방해줘요. 실제 시험에서 제품 사용 4주 후 피부 탄력 개선이 24.6%나 되었다는 결과가 나왔답니다.
피부 치밀도 개선

제품 사용 4주 후 피부 치밀도가 9.79% 개선되었어요. 위 사진은 시험 전과 후 비교 사진이랍니다!
눈가 주름 개선

제품 사용 4주 후 눈가 주름이 9.49% 개선되었다는 시험 결과도 있어요!
속광케어&쫀쫀한 탄력

수분광 피부를 만드는 '나이아신아마이드'와 쫀쫀하게 탄력을 잡아주는 '아데노신'은 식약처가 고시한 미백·주름개선 대표 성분으로 유효치만큼 처방해 투명한 피부톤과 주름을 개선해주는 성분이에요. 이 성분을 이용해 속광케어부터 쫀쫀 탄력까지 원스텝 케어를 도와요.
사용 만족도 100%

대한피부과학연구소에서 21명을 대상으로 평가를 진행했을 때, 수분이 날아가지 않고 촉촉하게 유지된다, 생기있고 컨디션이 좋아졌다, 속당김이 줄었다, 피부가 단력있고 탄탄해진 느낌이다라는 항목에서 모두 100% 응답을 받았어요.
부활초인 이유?

부활초는 사막에서도 소량의 수분으로 다시 꽃을 피우는 강인한 생명력을 가지고 있어요. 이 부활초가 피부 수분 통로 '아쿠아포린'을 활성화시켜 막혀있던 수분길을 열어주고, 수분과 유효 성분들을 피부 속 닿지 않는 곳까지 빈틈없이 전달해준답니다.
부활초의 효능

부활초의 뛰어난 수분보유능력 원천 성분 '글리세릴글루코사이드'가 아쿠아포린을 열어주면 피부 속까지 수분과 유효 성분이 흡수되어 피부 노화를 지연시키고 피부에 탄력과 윤기를 부여해줘요.
물로는 피부를 바꿀 수 없어요.

풍부한 수분과 깊은 보습감으로 피부 속까지 촉촉함을 채우는 고농축 수분 에너지 부활초 69%를 정제수 대신 가득 담았어요.
3-곡물 콜라겐 펩타이드

피부의 코어를 잡아 탄탄한 피부를 만드는 기존 동물성 펩타이드의 효능은 그대로하며, 슈퍼푸드 귀리, 콩, 밀 3가지 곡물로 비건 콜라겐 펩타이드로 자극 없이 순하고 쫀쫀한 단백질 장벽을 완성해보세요!
10겹 히알루론산

피부 표면 수분 보호막부터 각질층 수분 공급 및 보습까지 속까지 당기고 건조한 푸석푸석한 피부에 꽉 찬 수분감을 전달하는 10겹 히알루론산이 함유되어 있어요.
슬로우 비건 바이옴 2%

우리 몸에 이로운 비피더스 유산균과 현미 + 상화버섯 균사체를 360시간 저온 발효해 완성한 슬로우 비건 바이옴 포뮬라예요. 우리 피부에서 조화를 이루며 살고 있는 수십억의 스킨 마이크로바이옴을 케어해 피부 장벽을 탄탄하게 가꿔준답니다.
스킨 마이크로바이옴이란?

우리 몸에서 살아가면서 피부의 정상적인 기능을 돕는 미생물과 그 군집, 그리고 피부 미생물의 생태계를 총칭하는 말이에요.
한국 최초 KIND TO BIOME 인증
건강한 피부를 위한 좋은 스킨케어의 기준이 되는 KIND TO BIOME 인증으로 효능이 검증되었어요. 피부 속부터 건강한 수분을 더해 수분광 가득 건강한 피부를 선사해요.
속건조 케어 특화 텍스처

부드러운 발림성의 우윳빛 텍스처가 얼굴 전체에 윤기 가득 수분광을 선사하고, 피부 속까지 탄탄하고 촉촉하게 풍부한 보습감을 전달해줘요.
끈적임 적은 텍스처

속건조케어는 10, 수분광채는 8, 탄력감 8, 화장궁합은 7로 높은 스펙이며, 끈적임은 3으로 적기 때문에 기분 좋은 텍스처를 느끼실 수 있어요.
동물과 지구를 지키는 비건

동물성 원료를 사용하지 않는 비건 제품이며, 동물 실험을 하지 않는 CRUELTY FREE 제품이에요.
비건 화장품의 편견?

비건 화장품이라고 순하기만 하고 효과는 없는 건 아닐지, 하는 편견이 간혹 있는데요. 엄선한 채식주의 성분이 주는 피부 변화를 느껴보세요. 비건 성분으로 순하게 지속되는 효능과 변화된 피부를 확인하실 수 있을 거예요.
전성분

부활초 바이옴 속건조 앰플 전성분을 확인해보세요!
불필요한 성분 모두 제외

인공 향료 무첨가, 전성분 EWG green 등급, 20가지 유해 성분 무첨가, 알러지 유발 주의 성분 무첨가 제품이에요.
피부 자극 테스트 완료

부활초 바이옴 속건조 앰플 사용 후 48시간 경과 저자극 확인 했을 때 피부 반응도 0.0으로 피부 자극 테스트를 완료한 제품이랍니다.
약산성 앰플

피부와 가장 유사한 PH 5.0~7.0 약산성 제품이에요. 기초 제품 바꾸기 두려운 민감한 피부도 안심하고 사용할 수 있는 약산성 앰플이랍니다.
오랫동안 지속할 수 있도록

에필로우의 모든 제품은 환경을 생각하는 패키지에 담아 보내드려요. 조금 느리더라도 오랫동안 지속할 수 있는 슬로우뷰티를 위해 늘 환경을 우선 순위에 두고 있어요.
환경을 위한 패키지

재활용이 쉬운 무코팅 유리병과 리무버블 라벨을 사용하며, 산림 관리 협회 FSC 인증을 받은 친환경 인쇄용지로 만든 단상자 패키지를 사용해요.
꿀팁
보통 토너 단계 이후 사용을 많이 하는데, 토너 단계 스킵하고 첫 단계부터 사용하면 앰플 고유의 제형감을 더 잘 느낄 수 있다고 해요. 피부 컨디션에 따라 사용법을 변화하며 사용해보고 본인 피부에 맞게 사용하면 좋아요!
장점
피부에 자극을 주는 성분이 들어있지 않고, 속당김을 잡아주는 앰플이라 좋아요!
아쉬운 점
공병이 작은 편은 아니라서 휴대성은 좀 떨어지는 것 같아요.
유의할 점
다른 제품과 함께 사용할 경우 화학반응으로 트러블이 생길 수 있으니, 손등에 테스트 후 사용해보시길 권장해요!
오늘은 속건조 앰플에 대해 소개해보았는데요. 다음에는 새로운 제품 추천으로 찾아올게요~!
이 포스팅은 쿠팡 파트너스 활동의 일환으로, 이에 따른 일정액의 수수료를 제공받습니다.
'뷰티의 화신 > 앰플' 카테고리의 다른 글
| 광채, 탄력을 위한 연어앰플 (0) | 2023.11.01 |
|---|---|
| 세럼, 에센스 대신 사용할 수 있는 화이트닝 앰플 (0) | 2023.10.31 |
| 시카 성분 들어간 화장품(앰플, 세럼) 찾고 있다면? (0) | 2023.10.24 |
| 올리브영 앰플(기초화장품) 추천 (0) | 2023.10.23 |
| 항산화 앰플 찾고 있다면? (0) | 2023.10.18 |